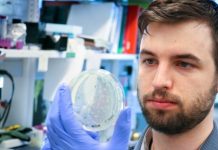
Mann award winner illuminates infectious diseases

Cornellian’s dairy waste startup wins NSF Phase II funding (Study)
Capro-X, a startup that repurposes dairy waste and began in Cornell Engineering’s Commercialization Fellows program, has...
National tick surveillance survey identifies gaps to be filled
New Cornell-led research shows that inadequate funding is the main barrier to better surveillance and control...
Tackling COVID-19: Dr Sharath Srinivasan (Study)
I’ve spent most of the last few years in Kenya and eastern Africa. When I wasn’t there, I was usually scampering back and forth...
Human interactions with wild and farmed animals must change dramatically to reduce risk of...
The authors of the new report argue that well-meaning but simplistic actions such as complete bans on hunting and wildlife trade, ‘wet markets’ or...
Evergreen idea turns biomass DNA into degradable materials (Study)
DNA has a lot of handy uses. It stores the blueprint of genetic code. It helps...
Study explores how multiple organs end up the same size
How do our arms stay the same length throughout development, from infancy to adulthood? Or how...
Steep NYC traffic toll would reduce gridlock, pollution (Study)
New York City is among the most congested traffic spots in the world.
Soon, in an effort...
Mann award winner illuminates infectious diseases
The bacteria Legionella pneumophila has been the favorite snack of certain water-borne amoeba for millions of...
Gerlinde Van de Walle: ‘There’s so much to investigate’
From an early age, Dr. Gerlinde Van de Walle wanted to be a veterinarian. Growing up...
Cornell earns STARS platinum sustainability rating (Study)
Cornell has earned a platinum sustainability rating – the top status – from the Association for...
Top News
Hey ISIS, You Suck: Local Muslims Post Anti-ISIS Billboard
A new billboard on Manchester Road in Missouri reads, "HEY ISIS, YOU SUCK!!! From: #ActualMuslims."
A group of Muslim-Americans have put up a blunt billboard...